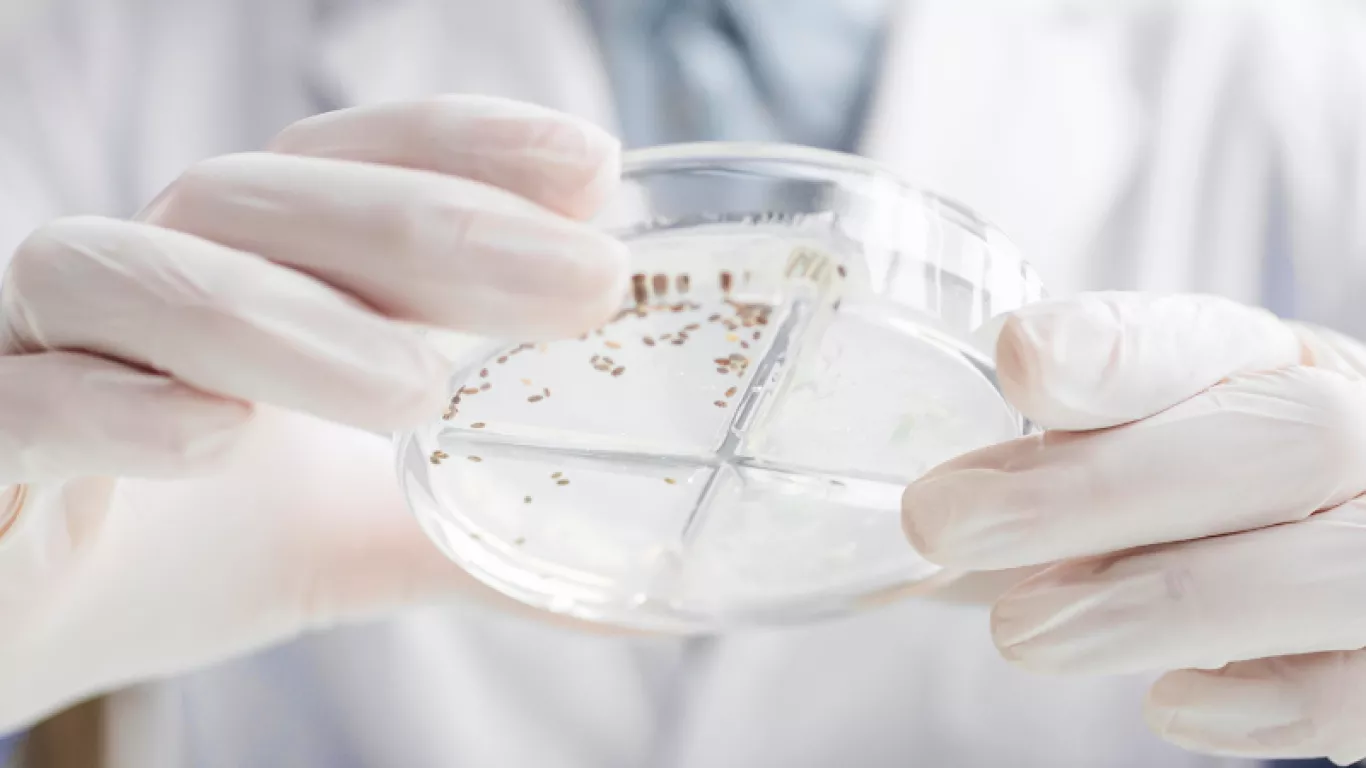
brote de IAAS

Publicidad
Publicidad
Acciones de Invima ante el brote de IAAS por Burkholderia spp en Colombia
Se trabaja para establecer si un medicamento fue la causa.
El Instituto Nacional de Vigilancia de Medicamentos y Alimentos (Invima) en cumplimiento de sus funciones institucionales ha venido acompañando a las diferentes entidades encargadas del seguimiento del brote por Burkholderia spp detectado en diferentes Instituciones Prestadoras de Servicios de Salud en Colombia, aportando información técnica con el fin de determinar si el medicamento Hidromorfona clorhidrato 2mg/ml en solución inyectable con número de registro sanitario INVIMA 2019M-0010014-R1, fue la causa que originó esta situación sanitaria.
Siendo, así las cosas, se informa que se realizaron las técnicas analítica prueba de detección de endotoxinas bacteriana y pruebas de esterilidad.
La ejecución de estas técnicas analíticas por parte de la Oficina de Laboratorios y Control de Calidad del Invima, la cuales, fueron realizadas sobre los lotes HMF -074, HMF -075, HMF -80, HMF -81, HMF – 82 del producto Hidromorfona clorhidrato 2mg/ml fabricados por Laboratorios Ryan de Colombia S.A.S, permitieron obtener resultados conformes y sin presencia de contaminación por Burkholderia spp o cualquier otro microorganismo.
Adicionalmente, estos resultados se encuentran acompañados por la visita de seguimiento a las Buenas Prácticas de Manufactura - BPM al fabricante Laboratorios Ryan de Colombia S.A.S, que, se consideró que mantiene el concepto establecido en la Resolución No. 2020045130 del 21/12/2020 por la cual se concedió el certificado de BPM para este establecimiento.
Por lo tanto, el Invima suspende las recomendaciones realizadas en el comunicado del día 27 de octubre del 2023, aclarando que los lotes del medicamento aquí mencionado pueden ser utilizados con seguridad en el tratamiento de los pacientes que lo requieran, puesto que no se identificaron riesgos que impidan su comercialización en el marco del Artículo 578 de la Ley 9 de 1979.
El Invima reitera su compromiso con la salud pública y la seguridad de los medicamentos en el país, y continúa trabajando de la mano con las autoridades locales de salud para investigar y tomar las medidas necesarias en caso de identificar cualquier riesgo para la población.
Le puede interesar:
Etiquetas